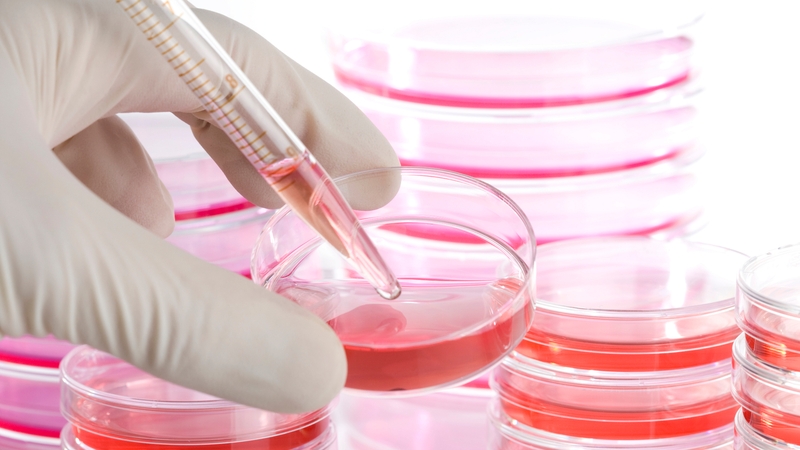
It is not yet clear how the technique would work in humans

Scientists in Britain have taken a significant step towards the possibility of reversing certain forms of blindness using stem cells.
For the first time, researchers have successfully grown light sensitive mouse retina cells from embryonic stem cells in the lab and transplanted them into night-blind mice.
Following the transplantation, the cells appeared to develop normally, by integrating into the existing retina and forming nerve connections needed to transmit visual information to the brain.
The findings are published in the latest edition of Nature Biotechnology.
It is not yet clear how the technique would work in humans.
There are two types of photoreceptors in the eyes, known as rods and cones.
Rods are important for night vision.
Using a new technique involving 3D culture and differentiation of mouse stem cells recently developed in Japan, the team grew retinas containing all the different nerve cells needed for sight.
They then transplanted 200,000 of the artificially grown photoreceptor cells into retina of the night blind mice.
Three weeks later a much smaller number of the cells had integrated into the mouse retina and had begun looking like normal mature rod cells.
They remained present six weeks after transplantation.
The scientists also saw nerve connections, giving rise to the suggestion that the cells were able to connect with the retina's nerve system.
Experts say the research is significant.
However, they say many more of the cells would have to successfully integrate into the recipient retina for the technique to be effective.
The group also did not assess whether the animals' vision was improved as this would have required a far larger number of transplantable cells than could be produced in this study.
The research group that carried out the study is led by Prof Robin Ali of University College London Institute of Ophthalmology and Moorfields Eye Hospital.
He is also the chief scientific advisor with Irish charity Fighting Blindness.
Fighting Blindness external affairs manager Anna Moran said: "Milestones like this are hugely significant in moving us one step closer to the clinic to ultimately deliver treatments for the 224,000 people currently affected by sight loss in this country."